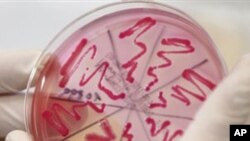
မြန်မာလူထုတွင်း E.Coli ပညာပေး

ဥရောပနိုင်ငံ တချို့မှာ လူတော်တော်များများ သေဆုံးခဲ့ရပြီး ကူးစက်မှု မြန်ဆန်လွန်းတဲ့ E. Coli ရောဂါပိုး စစ်ဆေးမှုတွေကို မြန်မာနိုင်ငံက စားသောက်ဆိုင်တွေ၊ လမ်းဘေးဈေးဆိုင်တွေနဲ့ ရေသန့်လုပ်ငန်းတွေမှာ ရှောင်တခင် လုပ်ဆောင်နေပြီလို့ မြန်မာနိုင်ငံက ကျန်းမာရေးဝန်ထမ်း အရာရှိကြီးတဦးက ပြောပါတယ်။ ဒါ့အပြင် ကျန်းမာရေးနဲ့ ပတ်သက်ပြီး ပညာပေးမှုတွေ နှေးကွေးတဲ့ မြန်မာနိုင်ငံမှာ ဒီရောဂါပိုးနဲ့ ပတ်သက်လို့ လူထုအကြား ပိုပြီး သတိရှိလာအောင် ကျယ်ကျယ်ပြန့်ပြန့် လုပ်ဆောင်သင့်တယ်လို့လည်း ဝေဖန်မှုတွေ ရှိနေပါတယ်။ အပြည့်အစုံကို မနန္ဒာချမ်းက တင်ပြပေးထားပါတယ်။
ဂျာမဏီနိုင်ငံ မြောက်ပိုင်းကနေ စတင်ဖြစ်ပွားလာခဲ့ပြီး အစားအစာ ဟင်းသီးဟင်းရွက်တွေကနေ အဓိက ကူးစက်လာတဲ့ ဒီ E. Coli ပိုးကြောင့် ကမ္ဘာမှာ လူ ၅၀ လောက် သေဆုံးခဲ့ရပြီး ထောင်ပေါင်းများစွာလည်း ရောဂါပိုး ကူးစက်တာကို ခံခဲ့ရတာပါ။ ဥရောပတလွှား ကူးစက်သွားတဲ့ ဒီရောဂါပိုး အမျိုးအစားဟာ အသစ်ဖြစ်တယ်ဆိုပြီး WHO ကမ္ဘာ့ကျန်းမာရေး အဖွဲ့ကြီးကလည်း သတိပေးထားခဲ့ပါတယ်။
ပြီးခဲ့တဲ့လကတော့ မြန်မာ့အိမ်နီးချင်း ထိုင်းနိုင်ငံမှာ E. Coli ပိုးကို တွေ့ရှိခဲ့တဲ့အကြောင်း ကျန်းမာရေး အရာရှိတွေက ကြေညာခဲ့ပါတယ်။ ဒါကြောင့် မြန်မာနိုင်ငံမှာလည်း ဒီပိုး ရှိ၊ မရှိ စားသောက်ဆိုင်တွေ၊ ရေသန့်လုပ်ငန်းတွေနဲ့ ဈေးဆိုင်တွေမှာ ရှောင်တခင် ဝင်ရောက် စစ်ဆေးတာတွေ၊ အစားအသောက်တွေကို နမူနာယူပြီး စစ်ဆေးတာတွေကိုပါ လုပ်ဆောင်နေတယ်လို့ FDA မြန်မာနိုင်ငံ အစားအသောက်နဲ့ ဆေးဝါးကွပ်ကဲရေးဌာန ညွှန်ကြားရေးမှူး ဒေါက်တာကျော်လင်းက ပြောပါတယ်။
“ကျနော်တို့ အခု အစားအသောက်မှာ ရှာဖွေနေတာပေါ့။ E.Coli နဲ့ ပတ်သက်တဲ့ဟာတွေ ယူပြီးတော့ စစ်တယ်လေ။ FDA အနေနဲ့ကတော့ အစားအသောက်တွေမှာ၊ သောက်ရေတွေ၊ အသုံးပြုတဲ့ ရေတွေမှာ E.Coli နဲ့ ပတ်သက်ပြီးတော့ ရှိလား၊ မရှိလားဆိုတဲ့ဟာကို ထောက်လှမ်းတဲ့အပိုင်း တပိုင်းပေါ့။ ဒီလို Monitoring System လေးတွေ ထားထားတာ ရှိပါတယ်။ E.Coli organism ကို ကျနော်တို့က ရှာနေတုန်းပဲပေါ့။ တွေ့တယ်ဆိုရင် ထုတ်ပြန်ပေးမှာပေါ့၊ ဒီဥစ္စာ။ ကျနော်တို့ အပိုင်းကတော့ ဒီလိုပဲ အမြဲတမ်း ထောက်လှမ်းနေတာပေါ့၊ E.Coli နဲ့ ပတ်သက်ပြီးတော့။”
ဒါပေမဲ့လည်း တချို့စားသောက်ဆိုင်တွေမှာ E. Coli ပိုး တွေ့ရှိရတယ်ဆိုပြီး သတင်းတွေ ထွက်ပေါ်ခဲ့ပါတယ်။ သက်ဆိုင်ရာ တာဝန်ရှိသူတွေဘက်ကတော့ ဒါကို အတိအကျ ထုတ်ပြန်တာ မရှိသေးပါဘူး။ လောလောဆယ်တော့ မြန်မာပြည်သူတွေအကြား ဒီပိုးနဲ့ ပတ်သက်တဲ့ ဗဟုသုတတွေ ပိုပြီး ကြွယ်ဝလာအောင် သတင်းမီဒီယာတွေကနေ တဆင့် ပညာပေးမှုတွေ လုပ်ဆောင်ပြီး ရှောင်ကြဉ်ရမယ့် အချက်တွေနဲ့ ပတ်သက်လို့ သတိပေးမှုတွေ လုပ်ဆောင်နေတယ်လို့လည်း ဒေါက်တာကျော်လင်းက အခုလို ဆက်ပြောခဲ့ပါတယ်။
“မြန်မာနိုင်ငံ အနေနဲ့ Food Color တွေ ဂရုစိုက်ပါတယ်။ Food Color Chemical တွေပေါ့။ ငရုတ်သီးမှုန့်မှာ ထည့်တာတို့၊ ဒါလေးတွေကို ကျနော်တို့က သေချာ စိစစ်ပြီးတော့ ပညာပေးတာပေး၊ နောက် ရောင်းတဲ့ဟာတွေလည်း ပညာပေးပေါ့။ ပညာပေးတဲ့ အပိုင်းနဲ့ပဲ သွားတာ ဖြစ်ပါတယ်။ အစားအသောက်နဲ့ ပတ်သက်လာရင်တော့ ပူပူနွေးနွေးစားဖို့ အရေးကြီးတာပေါ့။ နောက်ပြီးတော့ လက်ဆေးတာ၊ သန့်ရှင်းရေးတွေ၊ စားသောက်တဲ့ အိုးခွက် ပန်းကန်ကအစ သန့်သန့်ရှင်းရှင်းလုပ်ဖို့။ ပြီးတော့ အစားအသောက်ကိုလည်း ၂ နာရီထက် ကျော်သွားရင်တော့ ဘက်တီးရီးယား ပိုးတွေက ပေါက်တာပဲ။ အဲဒါတွေလည်း အန္တရာယ်ရှိတဲ့ အကြောင်းလေးပေါ့။ ဒါလေးတွေ ပြောချင်ပါတယ်။”
မြန်မာနိုင်ငံ အစားအသောက်နဲ့ ဆေးဝါးကွပ်ကဲရေးဌာန ညွှန်ကြားရေးမှူး ဒေါက်တာကျော်လင်း ပြောသွားခဲ့ပါ။
မြန်မာနိုင်ငံမှာက လမ်းဘေးဈေးဆိုင်တွေလည်း အရမ်းများလွန်းတဲ့အတွက် ဒီ E.Coli ပိုးနဲ့ ပတ်သက်လို့ အတော်လေး ကြပ်မတ် စစ်ဆေးနေရတယ်လို့လည်း သူက ပြောဆိုသွားခဲ့ပါတယ်။ အိမ်နီးချင်း ထိုင်းနိုင်ငံမှာ E. Coli ပိုးကို တွေ့ရှိခဲ့တာ ဥရောပက တင်ပို့တဲ့ ထောပတ်သီးကနေ ဖြစ်တယ်လို့ ကျန်းမာရေး အရာရှိတွေကို ကိုးကားပြီး သတင်းတွေမှာ ဖော်ပြခဲ့ကြပါတယ်။
ဒီပိုး ဘယ်ကနေ စပြီး သန္ဓေတည်လာခဲ့တယ် ဆိုတာကို အတိအကျ မသိရပေမဲ့ ဟင်းသီးဟင်းရွက်ကနေ တဆင့် ကူးစက်တာလို့တော့ ကျန်းမာရေး ပညာရှင်တွေက တွက်ဆကြပါတယ်။ ဒါကြောင့်လည်း ဥရောပတလွှားမှာရှိတဲ့ လယ်ယာလုပ်ငန်းရှင်တွေ အနေနဲ့ ယူရိုငွေ သန်းပေါင်းများစွာ ဆုံးရှုံးနစ်နာခဲ့ရတာ ဖြစ်ပါတယ်။